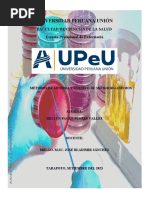

0% encontró este documento útil (0 votos)
177 vistas9 páginasImportancia y Clasificación de Microorganismos
El documento describe los microorganismos. Estos son seres vivos diminutos que solo pueden verse con microscopio y juegan un papel importante en los suelos. Incluyen bacterias, hongos, actinomicetos, protozoos, nematodos y virus. Estos microorganismos desempeñan funciones vitales como la descomposición de la materia orgánica y el ciclo de nutrientes en los suelos.
Cargado por
Edpa Duran MaciasDerechos de autor
© © All Rights Reserved
Nos tomamos en serio los derechos de los contenidos. Si sospechas que se trata de tu contenido, reclámalo aquí.
Formatos disponibles
Descarga como DOCX, PDF, TXT o lee en línea desde Scribd
0% encontró este documento útil (0 votos)
177 vistas9 páginasImportancia y Clasificación de Microorganismos
El documento describe los microorganismos. Estos son seres vivos diminutos que solo pueden verse con microscopio y juegan un papel importante en los suelos. Incluyen bacterias, hongos, actinomicetos, protozoos, nematodos y virus. Estos microorganismos desempeñan funciones vitales como la descomposición de la materia orgánica y el ciclo de nutrientes en los suelos.
Cargado por
Edpa Duran MaciasDerechos de autor
© © All Rights Reserved
Nos tomamos en serio los derechos de los contenidos. Si sospechas que se trata de tu contenido, reclámalo aquí.
Formatos disponibles
Descarga como DOCX, PDF, TXT o lee en línea desde Scribd